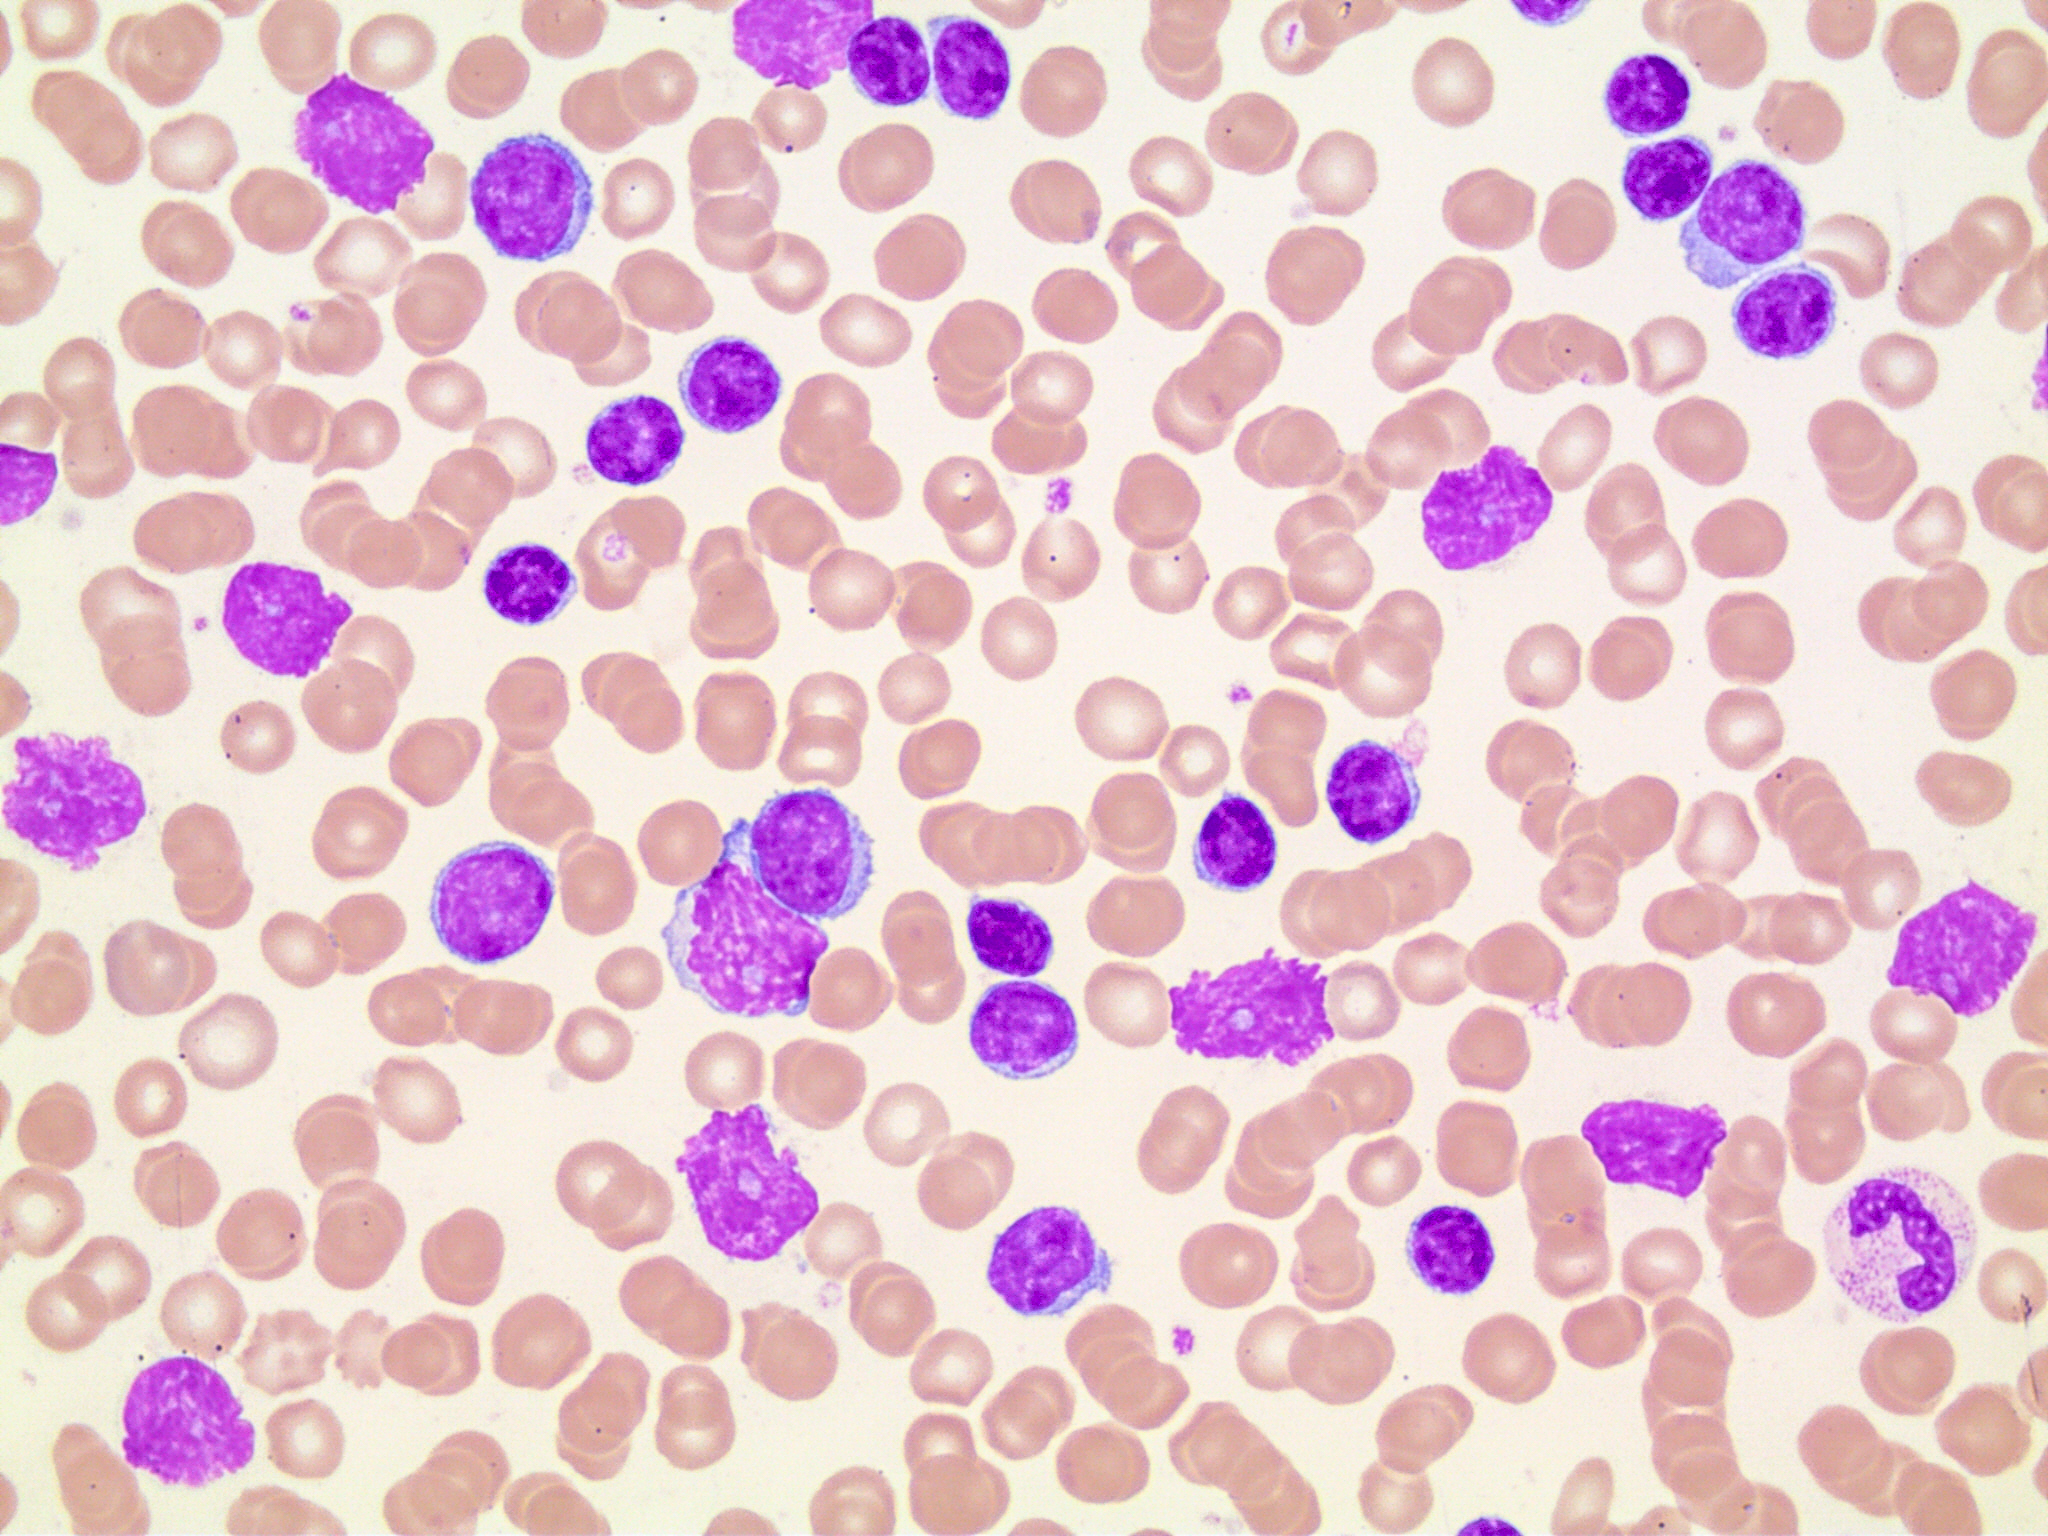

Kontakt
MVZ für Laboratoriumsmedizin und Mikrobiologie Koblenz-Mittelrhein
Viktoriastrasse 35-39
56068 Koblenz
Telefon
Öffnungszeiten
Die Zeiten der Durchführung der Laboranalytik an unserem Standort in Koblenz sind abhängig von dem jeweiligen Untersuchungsbereich und finden in der Regel werktäglich, teilweise im 24/7-Betrieb statt.
| Praxissprechzeiten | Gerinnungsambulanz | Blutentnahmen | telefonische Erreichbarkeit / Befundauskunft | |
| Montag | 08:00 – 16:00* | 07:30 – 11:30 13:30 – 15:30** |
08:30 – 12:00*** | 07:30 – 20:00 |
| Dienstag | 08:00 – 16:00* | 07:30 – 12:00 13:30 – 16:00** |
08:30 – 12:00*** | 07:30 – 20:00 |
| Mittwoch | 08:00 – 16:00* | 07:30 – 12:00** | 08:30 – 12:00*** | 07:30 – 20:00 |
| Donnerstag | 08:00 – 16:00* | 07:30 – 11:30 13:30 – 15:30** |
08:30 – 12:00*** | 07:30 – 20:00 |
| Freitag | 08:00 – 16:00* | 07:30 – 11:30 13:30 – 15:30** |
08:30 – 12:00*** | 07:30 – 20:00 |
| Samstag | Geschlossen | Geschlossen | Geschlossen | Geschlossen |
| Sonntag | Geschlossen | Geschlossen | Geschlossen | Geschlossen |
* Der generelle Zutritt zu unseren Laborräumlichkeiten wird auf unbestimmte Zeit eingeschränkt und nur im Einzelfall nach telefonischer Anmeldung gewährt.
** Zum aktuellen Zeitpunkt nur nach telefonischer Terminvereinbarung! Gerinnungsambulanz: 0261 30405-895
*** Zum aktuellen Zeitpunkt nur nach telefonischer Terminvereinbarung!
0261 30405-0
Anfahrt
Parkmöglichkeiten
Forum Mittelrhein
Parkhaus ADAC
Rhein-Mosel-Halle
Löhr-Center
Schängelcenter
Öffentliche Parkmöglichkeiten
Sie sehen gerade einen Platzhalterinhalt von Google Maps. Um auf den eigentlichen Inhalt zuzugreifen, klicken Sie auf die Schaltfläche unten. Bitte beachten Sie, dass dabei Daten an Drittanbieter weitergegeben werden.
Mehr InformationenMVZ für Laboratoriumsmedizin und Mikrobiologie Koblenz-Mittelrhein
Partnerschaft im Sinne
des Patientenwohls
Wir sehen uns als Partner und Dienstleister des behandelnden Arztes. Unsere Arbeit dient der Unterstützung und Entlastung in dessen Arbeitsalltag, um gemeinsam das individuell bestmögliche Therapieergebnis für jeden einzelnen Patienten zu erzielen. Hierzu ist es unser eigener Anspruch, dem Arzt die Befundergebnisse schnellstmöglich bereitzustellen und in Fachfragen kompetent zu beraten. Moderne und benutzerfreundliche EDV-Systeme
sind hier für beide Seiten als Helfer nützlich.
Qualität und
Zuverlässigkeit
Im Bewusstsein unserer Verantwortung als spezialisierter Anbieter
im Gesundheitssystem, stehen die Qualität unserer Leistungen und
die Zuverlässigkeit unserer Untersuchungsergebnisse für uns an
oberster Stelle. Zur Gewährleistung einer qualitativ hochwertigen Analytik stellen wir hohe Anforderungen an unsere Mitarbeiter sowie unsere medizinische und technische Ausrüstung.
Regionalität
Als unsere Heimat sehen wir Koblenz und das gesamte Mittelrheintal.
Dies spiegelt sich auch in unserem Namen wider. Als MVZ für Laboratoriumsmedizin und Mikrobiologie Koblenz-Mittelrhein präsentieren wir uns als Teil dieser Region und setzen uns regelmäßig für Bildung, Kultur und Sport ein.
Zukunftsorientierung
Unter der Berücksichtigung zukünftiger gesundheitspolitischer und
medizinischer Herausforderungen arbeiten wir kontinuierlich an der
Weiterentwicklung unserer Abläufe und Systeme. Hierbei beachten wir die Wechselwirkungen zwischen Innovation, Effizienz, Qualität und Zuverlässigkeit
Nachhaltigkeit
Unter Nachhaltigkeit verstehen wir es, die labormedizinische Versorgung in der Region zukunftssicher zu gestalten. Wir sehen uns in der Pflicht, auf die Bedürfnisse und Wünsche der Ärzte am Patienten einzugehen und die Weichen für eine nachhaltige Partnerschaft zu stellen. Unsere Mitarbeiter sind es, die unser Leitbild verkörpern, sodass eine nachhaltige Personalpolitik für uns von großer Bedeutung ist. Nicht zuletzt sind wir uns unserer Verantwortung gegenüber unserer Umwelt bewusst und fühlen uns
verpflichtet, dies im Rahmen unseres Arbeitsalltags zu berücksichtigen.
Partnerschaft im Sinne
des Patientenwohls
Wir sehen uns als Partner und Dienstleister des behandelnden Arztes. Unsere Arbeit dient der Unterstützung und Entlastung in dessen Arbeitsalltag, um gemeinsam das individuell bestmögliche Therapieergebnis für jeden einzelnen Patienten zu erzielen. Hierzu ist es unser eigener Anspruch, dem Arzt die Befundergebnisse schnellstmöglich bereitzustellen und in Fachfragen kompetent zu beraten. Moderne und benutzerfreundliche EDV-Systeme
sind hier für beide Seiten als Helfer nützlich.
Qualität und
Zuverlässigkeit
Im Bewusstsein unserer Verantwortung als spezialisierter Anbieter
im Gesundheitssystem, stehen die Qualität unserer Leistungen und
die Zuverlässigkeit unserer Untersuchungsergebnisse für uns an
oberster Stelle. Zur Gewährleistung einer qualitativ hochwertigen Analytik stellen wir hohe Anforderungen an unsere Mitarbeiter sowie unsere medizinische und technische Ausrüstung.
Regionalität
Als unsere Heimat sehen wir Koblenz und das gesamte Mittelrheintal.
Dies spiegelt sich auch in unserem Namen wider. Als MVZ für Laboratoriumsmedizin und Mikrobiologie Koblenz-Mittelrhein präsentieren wir uns als Teil dieser Region und setzen uns regelmäßig für Bildung, Kultur und Sport ein.
Zukunftsorientierung
Unter der Berücksichtigung zukünftiger gesundheitspolitischer und
medizinischer Herausforderungen arbeiten wir kontinuierlich an der
Weiterentwicklung unserer Abläufe und Systeme. Hierbei beachten wir die Wechselwirkungen zwischen Innovation, Effizienz, Qualität und Zuverlässigkeit
Nachhaltigkeit
Unter Nachhaltigkeit verstehen wir es, die labormedizinische Versorgung in der Region zukunftssicher zu gestalten. Wir sehen uns in der Pflicht, auf die Bedürfnisse und Wünsche der Ärzte am Patienten einzugehen und die Weichen für eine nachhaltige Partnerschaft zu stellen. Unsere Mitarbeiter sind es, die unser Leitbild verkörpern, sodass eine nachhaltige Personalpolitik für uns von großer Bedeutung ist. Nicht zuletzt sind wir uns unserer Verantwortung gegenüber unserer Umwelt bewusst und fühlen uns
verpflichtet, dies im Rahmen unseres Arbeitsalltags zu berücksichtigen.